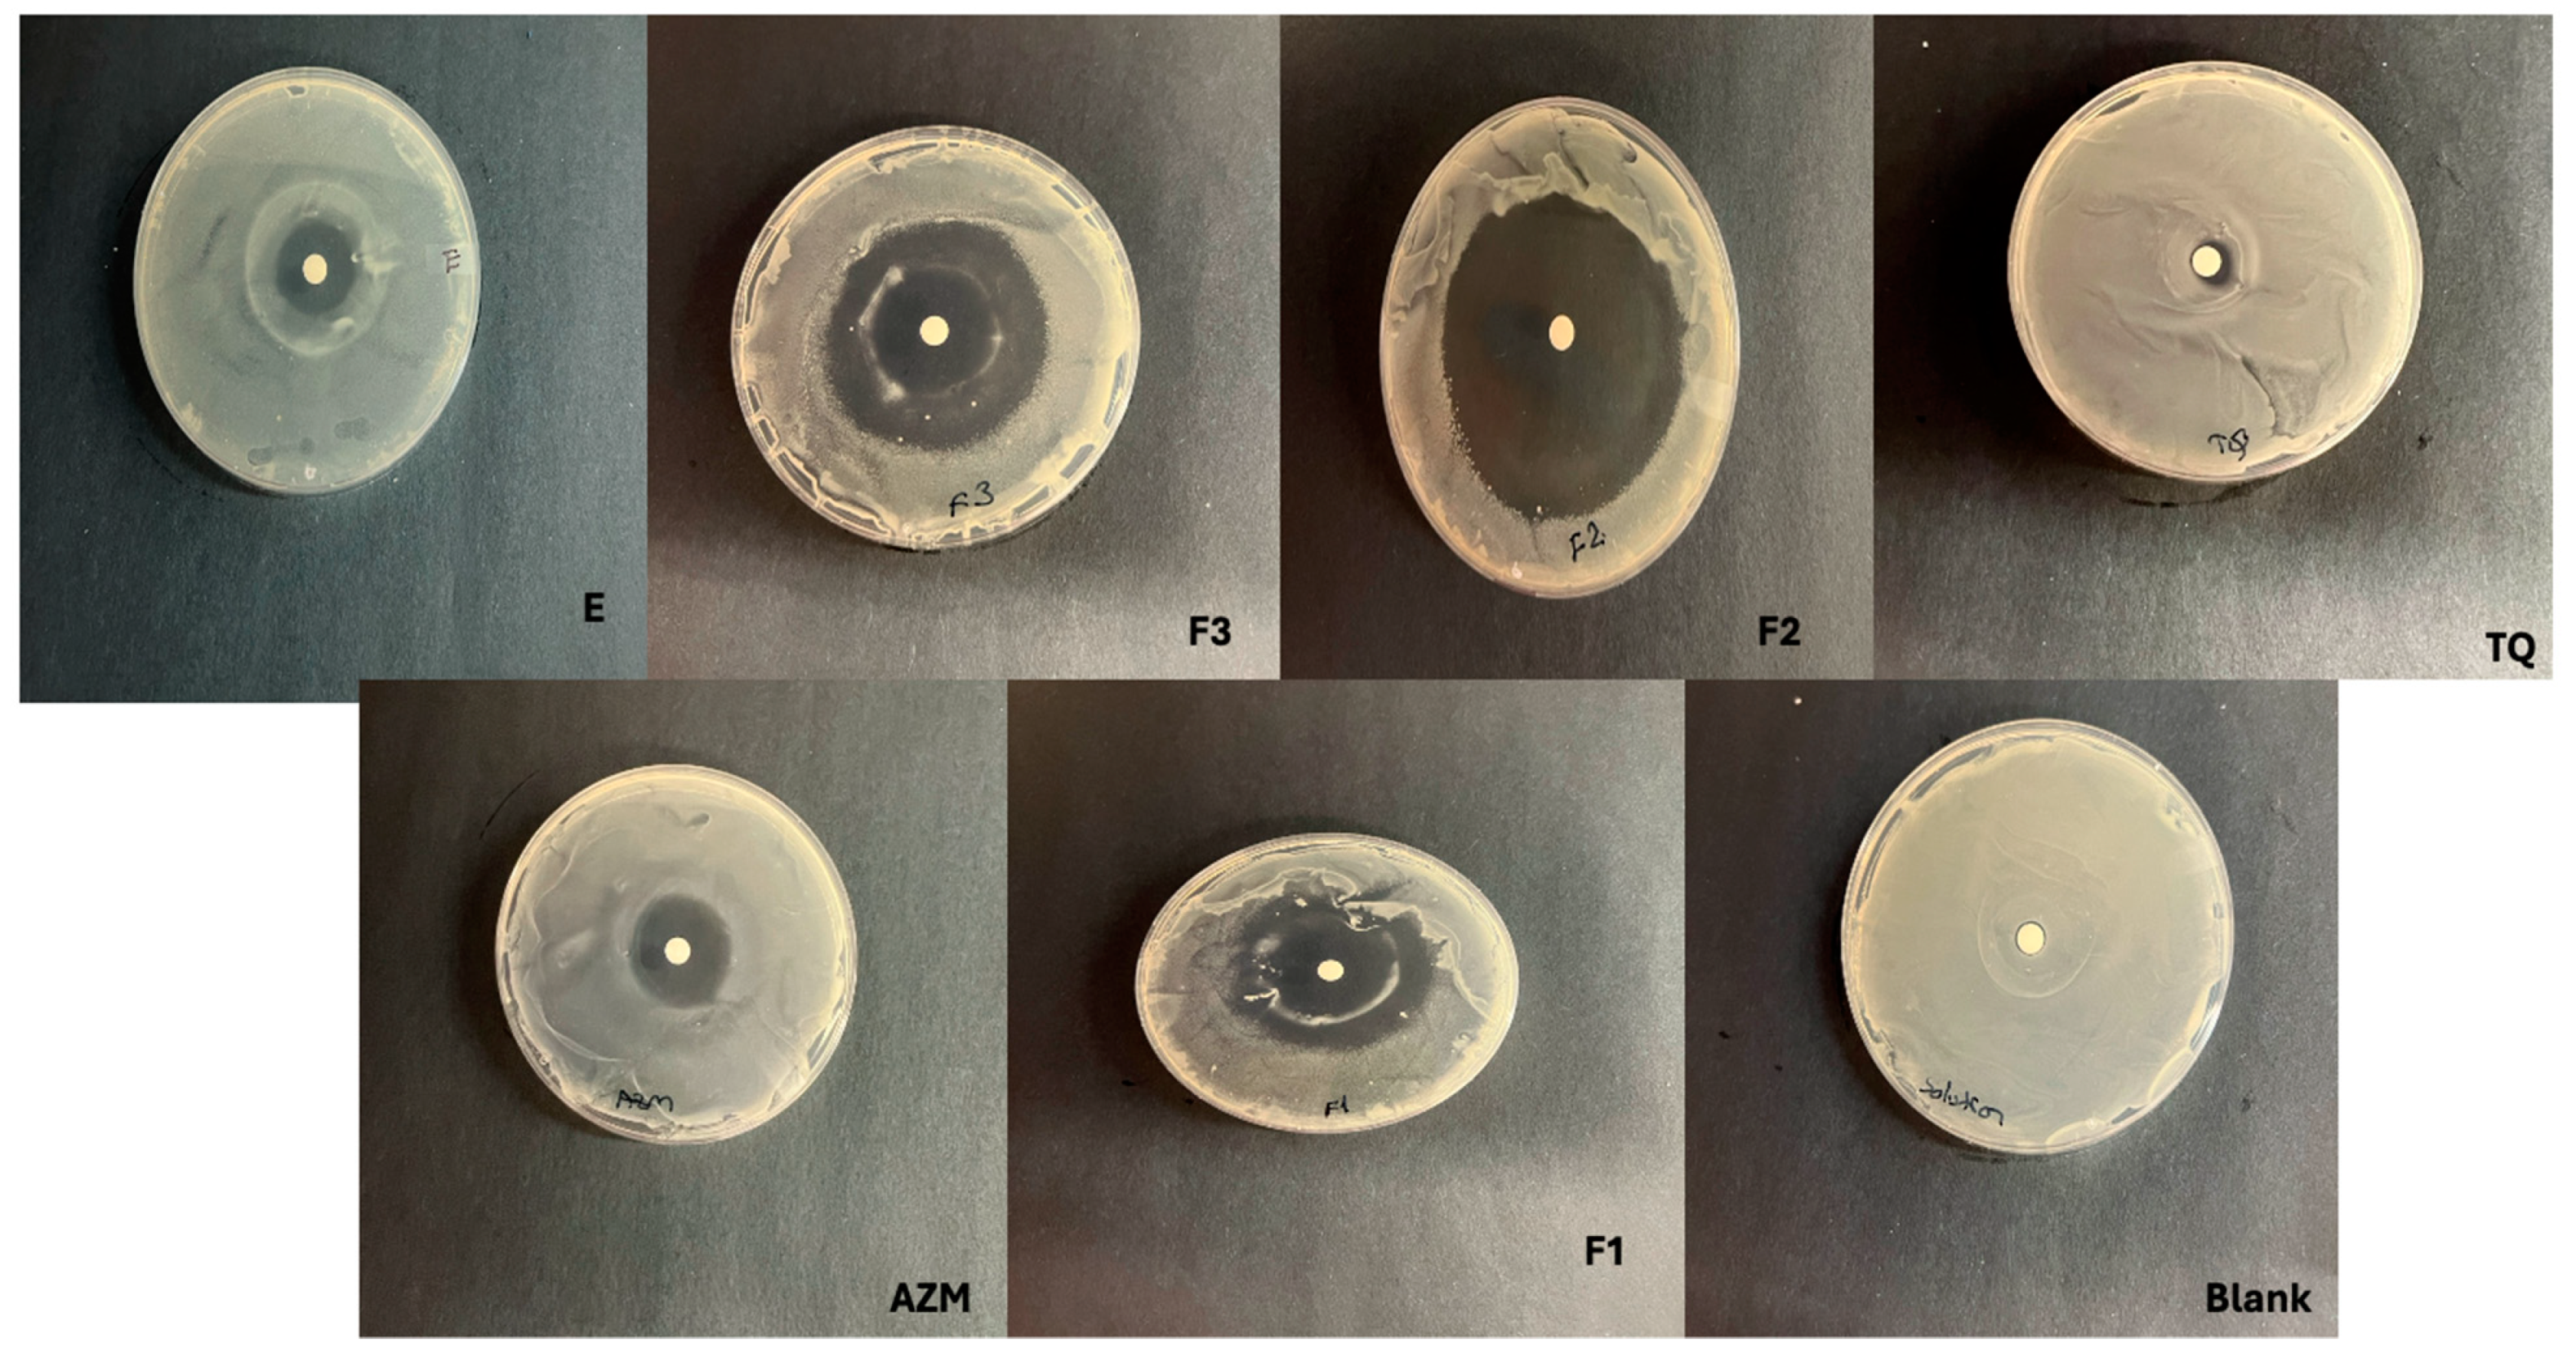
Scipharm 92 00029 g004

Effect of Edge Activator Combinations in Transethosomal Formulations for Skin Delivery of Thymoquinone via Langmuir Technique
Abstract
1. Introduction
2. Materials and Methods
2.1. Materials
2.2. Methods
2.2.1. Monolayer Study
2.2.2. Preparation of Ethosome and Transethosome Formulations with Thymoquinone
2.2.3. Characterization of Ethosomes and Transethosomes
2.2.4. Entrapment Efficiency (EE)
2.2.5. High-Performance Liquid Chromatography (HPLC)
2.2.6. In Vitro Skin Permeation Study
2.2.7. Skin Deposition Study
2.2.8. Antimicrobial Assay
2.2.9. Cytotoxicity Assay
2.2.10. Statistical Analysis
3. Results and Discussion
3.1. A Monolayer Study
3.2. Characterization of TQ-Loaded Ethosomes and Transethosomes and the Effect of Different Edge Activators
3.3. Ex Vivo Skin Deposition and Permeation Study
3.4. Antimicrobial Assay
3.5. Cytotoxicity Study
4. Conclusions
Author Contributions
Funding
Institutional Review Board Statement
Informed Consent Statement
Data Availability Statement
Conflicts of Interest
Abbreviations
| TQ | Thymoquinone |
| SLS | Sodium lauryl sulfate |
| SLG | Sodium lauroyl glutamate |
| Ph90 | Phospholipon 90G |
| IVPT | In vitro permeation testing |
References
- Qureshi, K.A.; Imtiaz, M.; Al Nasr, I.; Koko, W.S.; Khan, T.A.; Jaremko, M.; Fatmi, M.Q. Antiprotozoal Activity of Thymoquinone (2-Isopropyl-5-methyl-1,4-benzoquinone) for the Treatment of Leishmania Major-Induced Leishmaniasis: In Silico and In Vitro Studies. Antibiotics 2022, 11, 1206. [Google Scholar] [CrossRef] [PubMed]
- Ahmad, A.; Husain, A.; Mujeeb, M.; Alam Khan, S.; Najmi, A.K.; Siddique, N.A.; Damanhouri, Z.A.; Anwar, F. A review on therapeutic potential of Nigella sativa: A miracle herb. Asian Pac. J. Trop. Biomed. 2013, 3, 337–352. [Google Scholar] [CrossRef] [PubMed]
- Chaieb, K.; Kouidhi, B.; Jrah, H.; Mahdouani, K.; Bakhrouf, A. Antibacterial activity of Thymoquinone, an active principle of Nigella sativa and its potency to prevent bacterial biofilm formation. BMC Complement. Altern. Med. 2011, 11, 29. [Google Scholar] [CrossRef] [PubMed]
- Kohandel, Z.; Farkhondeh, T.; Aschner, M.; Samarghandian, S. Anti-inflammatory effects of thymoquinone and its protective effects against several diseases. Biomed. Pharmacother. 2021, 138, 111492. [Google Scholar] [CrossRef]
- Isaev, N.K.; Genrikhs, E.E.; Stelmashook, E.V. Antioxidant Thymoquinone and Its Potential in the Treatment of Neurological Diseases. Antioxidants 2023, 12, 433. [Google Scholar] [CrossRef]
- Salama, B.; Alzahrani, K.J.; Alghamdi, K.S.; Al-Amer, O.; Hassan, K.E.; Elhefny, M.A.; Albarakati, A.J.A.; Alharthi, F.; Althagafi, H.A.; Al Sberi, H.; et al. Silver Nanoparticles Enhance Oxidative Stress, Inflammation, and Apoptosis in Liver and Kidney Tissues: Potential Protective Role of Thymoquinone. Biol. Trace Element Res. 2023, 201, 2942–2954. [Google Scholar] [CrossRef] [PubMed]
- Ghorbanibirgani, A.; Khalili, A.; Rokhafrooz, D. Comparing Nigella sativa Oil and Fish Oil in Treatment of Vitiligo. Iran. Red Crescent Med. J. 2014, 16, e4515. [Google Scholar] [CrossRef] [PubMed]
- Hwang, J.R.; Cartron, A.M.; Khachemoune, A. A review of Nigella sativa plant-based therapy in dermatology. Int. J. Dermatol. 2021, 60, e493–e499. [Google Scholar] [CrossRef] [PubMed]
- Sakib, R.; Caruso, F.; Aktar, S.; Belli, S.; Kaur, S.; Hernandez, M.; Rossi, M. Antioxidant Properties of Thymoquinone, Thymohydroquinone and Black Cumin (Nigella sativa L.) Seed Oil: Scavenging of Superoxide Radical Studied Using Cyclic Voltammetry, DFT and Single Crystal X-ray Diffraction. Antioxidants 2023, 12, 607. [Google Scholar] [CrossRef] [PubMed]
- Badary, O.A.; Taha, R.A.; El-Din, A.M.G.; Abdel-Wahab, M.H. Thymoquinone Is a Potent Superoxide Anion Scavenger. Drug Chem. Toxicol. 2003, 26, 87–98. [Google Scholar] [CrossRef] [PubMed]
- Mansour, M.A.; Nagi, M.N.; El-Khatib, A.S.; Al-Bekairi, A.M. Effects of thymoquinone on antioxidant enzyme activities, lipid peroxidation and DT-diaphorase in different tissues of mice: A possible mechanism of action. Cell Biochem. Funct. 2002, 20, 143–151. [Google Scholar] [CrossRef] [PubMed]
- Algahtani, M.S.; Ahmad, M.Z.; Shaikh, I.A.; Abdel-Wahab, B.A.; Nourein, I.H.; Ahmad, J. Thymoquinone Loaded Topical Nanoemulgel for Wound Healing: Formulation Design and In-Vivo Evaluation. Molecules 2021, 26, 3863. [Google Scholar] [CrossRef] [PubMed]
- Bhattacharya, S.; Ahir, M.; Patra, P.; Mukherjee, S.; Ghosh, S.; Mazumdar, M.; Chattopadhyay, S.; Das, T.; Chattopadhyay, D.; Adhikary, A. PEGylated-thymoquinone-nanoparticle mediated retardation of breast cancer cell migration by deregulation of cytoskeletal actin polymerization through miR-34a. Biomaterials 2015, 51, 91–107. [Google Scholar] [CrossRef] [PubMed]
- Moghaddam, B.; Ali, M.H.; Wilkhu, J.; Kirby, D.J.; Mohammed, A.R.; Zheng, Q.; Perrie, Y. The application of monolayer studies in the understanding of liposomal formulations. Int. J. Pharm. 2011, 417, 235–244. [Google Scholar] [CrossRef] [PubMed]
- Negi, P.; Sharma, I.; Hemrajani, C.; Rathore, C.; Bisht, A.; Raza, K.; Katare, O.P. Thymoquinone-loaded lipid vesicles: A promising nanomedicine for psoriasis. BMC Complement. Altern. Med. 2019, 19, 334. [Google Scholar] [CrossRef] [PubMed]
- Sguizzato, M.; Ferrara, F.; Hallan, S.S.; Baldisserotto, A.; Drechsler, M.; Malatesta, M.; Costanzo, M.; Cortesi, R.; Puglia, C.; Valacchi, G.; et al. Ethosomes and Transethosomes for Mangiferin Transdermal Delivery. Antioxidants 2021, 10, 768. [Google Scholar] [CrossRef] [PubMed]
- Matharoo, N.; Mohd, H.; Michniak-Kohn, B. Transferosomes as a transdermal drug delivery system: Dermal kinetics and recent developments. Wiley Interdiscip. Rev. Nanomed. Nanobiotechnol. 2023, 16, e1918. [Google Scholar] [CrossRef] [PubMed]
- Ashtikar, M.; Nagarsekar, K.; Fahr, A. Transdermal delivery from liposomal formulations—Evolution of the technology over the last three decades. J. Control. Release 2016, 242, 126–140. [Google Scholar] [CrossRef] [PubMed]
- Verma, P.; Pathak, K. Therapeutic and cosmeceutical potential of ethosomes: An overview. J. Adv. Pharm. Technol. Res. 2010, 1, 274–282. [Google Scholar] [CrossRef] [PubMed]
- Gupta, R.; Kumar, A. Transfersomes: The Ultra-Deformable Carrier System for Non-Invasive Delivery of Drug. Curr. Drug Deliv. 2021, 18, 408–420. [Google Scholar] [CrossRef] [PubMed]
- Grossi, L.N.; Braz, W.R.; da Silva, N.P.; Cazarim, E.L.C.C.; Palmieri, M.G.S.; Tavares, G.D.; Pittella, F. Ethosomes as delivery system for treatment of melanoma: A mini-review. Oncologie 2023, 25, 455–459. [Google Scholar] [CrossRef]
- Das, S.K.; Chakraborty, S.; Roy, C.; Rajabalaya, R.; Mohaimin, A.W.; Khanam, J.; Nanda, A.; David, S.R. Ethosomes as Novel Vesicular Carrier: An Overview of the Principle, Preparation and its Applications. Curr. Drug Deliv. 2018, 15, 795–817. [Google Scholar] [CrossRef] [PubMed]
- Lazaridis, N.; Alexopoulos, A.; Chatzi, E.; Kiparissides, C. Steric stabilization in emulsion polymerization using oligomeric nonionic surfactants. Chem. Eng. Sci. 1999, 54, 3251–3261. [Google Scholar] [CrossRef]
- Elsayed, M.M.; Abdallah, O.Y.; Naggar, V.F.; Khalafallah, N.M. Deformable liposomes and ethosomes: Mechanism of enhanced skin delivery. Int. J. Pharm. 2006, 322, 60–66. [Google Scholar] [CrossRef] [PubMed]
- Raj, A.; Dua, K.; Nair, R.S.; Chandran, C.S.; Alex, A.T. Transethosome: An ultra-deformable ethanolic vesicle for enhanced transdermal drug delivery. Chem. Phys. Lipids 2023, 255, 105315. [Google Scholar] [CrossRef] [PubMed]
- Zhang, W.; Gao, Z.; Zhu, H.; Zhang, Q. Mixed micellization of cationic/anionic amino acid surfactants: Synergistic effect of sodium lauroyl glutamate and alkyl tri-methyl ammonium chloride. J. Dispers. Sci. Technol. 2022, 43, 2227–2239. [Google Scholar] [CrossRef]
- Zhao, S.; Yang, X.; Garamus, V.M.; Handge, U.A.; Bérengère, L.; Zhao, L.; Salamon, G.; Willumeit, R.; Zou, A.; Fan, S. Mixture of Nonionic/Ionic Surfactants for the Formulation of Nanostructured Lipid Carriers: Effects on Physical Properties. Langmuir 2014, 30, 6920–6928. [Google Scholar] [CrossRef] [PubMed]
- Vatanparast, H.; Shahabi, F.; Bahramian, A.; Javadi, A.; Miller, R. The Role of Electrostatic Repulsion on Increasing Surface Activity of Anionic Surfactants in the Presence of Hydrophilic Silica Nanoparticles. Sci. Rep. 2018, 8, 7251. [Google Scholar] [CrossRef] [PubMed]
- Rojewska, M.; Smułek, W.; Grzywaczyk, A.; Kaczorek, E.; Prochaska, K. Study of Interactions between Saponin Biosurfactant and Model Biological Membranes: Phospholipid Monolayers and Liposomes. Molecules 2023, 28, 1965. [Google Scholar] [CrossRef] [PubMed]
- Szczes, A.; Jurak, M.; Chibowski, E. Stability of binary model membranes-Prediction of the liposome stability by the Langmuir monolayer study (vol 372, pg 212, 2012). J. Colloid Interface Sci. 2014, 435, 199. [Google Scholar] [CrossRef]
- Yang, L.; Wu, L.; Wu, D.; Shi, D.; Wang, T.; Zhu, X. Mechanism of transdermal permeation promotion of lipophilic drugs by ethosomes. Int. J. Nanomed. 2017, 12, 3357–3364. [Google Scholar] [CrossRef] [PubMed]
- Duangjit, S.; Obata, Y.; Sano, H.; Onuki, Y.; Opanasopit, P.; Ngawhirunpat, T.; Miyoshi, T.; Kato, S.; Takayama, K. Comparative Study of Novel Ultradeformable Liposomes: Menthosomes, Transfersomes and Liposomes for Enhancing Skin Permeation of Meloxicam. Biol. Pharm. Bull. 2014, 37, 239–247. [Google Scholar] [CrossRef] [PubMed]
- Abdellatif, M.M.; Khalil, I.A.; Khalil, M.A. Sertaconazole nitrate loaded nanovesicular systems for targeting skin fungal infection: In-vitro, ex-vivo and in-vivo evaluation. Int. J. Pharm. 2017, 527, 1–11. [Google Scholar] [CrossRef] [PubMed]
- Haq, A.; Michniak-Kohn, B. Effects of solvents and penetration enhancers on transdermal delivery of thymoquinone: Permeability and skin deposition study. Drug Deliv. 2018, 25, 1943–1949. [Google Scholar] [CrossRef] [PubMed]
- Virani, A.; Puri, V.; Mohd, H.; Michniak-Kohn, B. Effect of Penetration Enhancers on Transdermal Delivery of Oxcarbazepine, an Antiepileptic Drug Using Microemulsions. Pharmaceutics 2023, 15, 183. [Google Scholar] [CrossRef] [PubMed]
- Virani, A.; Dholaria, N.; Mohd, H.; Albayati, N.; Michniak-Kohn, B. Effect of chemical penetration enhancers on the transdermal delivery of olanzapine in human skin in vitro. AAPS Open 2024, 10, 4. [Google Scholar] [CrossRef]
- Dvořáková, K.; Štěpánek, P.; Kroupová, J.; Zbytovská, J. N-Alkylmorpholines: Potent Dermal and Transdermal Skin Permeation Enhancers. Pharmaceutics 2021, 14, 64. [Google Scholar] [CrossRef] [PubMed]
- Virani, A.; Dholaria, N.; Matharoo, N.; Michniak-Kohn, B. A Study of Microemulsion Systems for Transdermal Delivery of Risperidone Using Penetration Enhancers. J. Pharm. Sci. 2023, 112, 3109–3119. [Google Scholar] [CrossRef] [PubMed]
- Dopierała, K.; Syguda, A.; Wojcieszak, M.; Materna, K. Effect of 1-alkyl-1-methylpiperidinium bromides on lipids of fungal plasma membrane and lung surfactant. Chem. Phys. Lipids 2022, 248, 105240. [Google Scholar] [CrossRef]
- Khattari, Z.; Langer, U.; Aliaskarisohi, S.; Ray, A.; Fischer, T. Effects of soluble surfactants on the Langmuir monolayers compressibility: A comparative study using interfacial isotherms and fluorescence microscopy. Mater. Sci. Eng. C 2011, 31, 1711–1715. [Google Scholar] [CrossRef]
- McConlogue, C.W.; Malamud, D.; Vanderlick, T. Interaction of DPPC monolayers with soluble surfactants: Electrostatic effects of membrane perturbants. Biochim. Biophys. Acta (BBA)-Biomembr. 1998, 1372, 124–134. [Google Scholar] [CrossRef]
- Balata, G.F.; Faisal, M.M.; Elghamry, H.A.; Sabry, S.A. Preparation and Characterization of Ivabradine HCl Transfersomes for Enhanced Transdermal Delivery. J. Drug Deliv. Sci. Technol. 2020, 60, 101921. [Google Scholar] [CrossRef]
- González-Rodríguez, M.L.; Arroyo, C.M.; Cózar-Bernal, M.J.; González-R, P.L.; León, J.M.; Calle, M.; Canca, D.; Rabasco, A.M. Deformability properties of timolol-loaded transfersomes based on the extrusion mechanism. Statistical optimization of the process. Drug Dev. Ind. Pharm. 2016, 42, 1683–1694. [Google Scholar] [CrossRef] [PubMed]
- Zhang, Z.J.; Osmałek, T.; Michniak-Kohn, B. Deformable Liposomal Hydrogel for Dermal and Transdermal Delivery of Meloxicam. Int. J. Nanomed. 2020, 15, 9319–9335. [Google Scholar] [CrossRef] [PubMed]
- Ban, E.; Park, M.; Jeong, S.; Kwon, T.; Kim, E.-H.; Jung, K.; Kim, A. Poloxamer-Based Thermoreversible Gel for Topical Delivery of Emodin: Influence of P407 and P188 on Solubility of Emodin and Its Application in Cellular Activity Screening. Molecules 2017, 22, 246. [Google Scholar] [CrossRef] [PubMed]
- Song, C.K.; Balakrishnan, P.; Shim, C.K.; Chung, S.J.; Chong, S.; Kim, D.D. A novel vesicular carrier, transethosome, for enhanced skin delivery of voriconazole: Characterization and in vitro/in vivo evaluation. Colloids Surf. B Biointerfaces 2012, 92, 299–304. [Google Scholar] [CrossRef] [PubMed]
- El Zaafarany, G.M.; Awad, G.A.S.; Holayel, S.M.; Mortada, N.D. Role of edge activators and surface charge in developing ultradeformable vesicles with enhanced skin delivery. Int. J. Pharm. 2010, 397, 164–172. [Google Scholar] [CrossRef] [PubMed]
- Nikolic, P.; Mudgil, P. The Cell Wall, Cell Membrane and Virulence Factors of Staphylococcus aureus and Their Role in Antibiotic Resistance. Microorganisms 2023, 11, 259. [Google Scholar] [CrossRef] [PubMed]

| Formula | TQ (% w/w) | Tween 20 (% w/w) | SLS (% w/w) | SLG (% w/w) | Ethanol (% w/w) | Ph90 (% w/w) | PBS |
|---|---|---|---|---|---|---|---|
| F1 | 0.2 | 0.5 | - | - | 50 | 3 | q.s. |
| F2 | 0.2 | 0.4 | 0.1 | - | 50 | 3 | q.s. |
| F3 | 0.2 | 0.4 | - | 0.1 | 50 | 3 | q.s. |
| E | 0.2 | - | - | - | 50 | 3 | q.s. |
| Formula Code | Zeta Average (nm) | PDI | EE% | Zeta Potential (mV) |
|---|---|---|---|---|
| F1 | 133.76 ± 1.26 | 0.20 ± 0.03 | 87% ± 0.34 | −20 ± 0.3 |
| F2 | 115.49 ± 0.72 | 0.19 ± 0.01 | 94% ± 0.26 | −62 ± 0.4 |
| F3 | 154.67 ± 2.68 | 0.22 ± 0.02 | 92% ± 0.35 | −32 ± 0.6 |
| E | 164.14 ± 5.05 | 0.12 ± 0.02 | 81% ± 0.41 | −38 ± 0.2 |
| Formulation | Jss (μg cm−2 h −1) | Kp (cm h−1) | Enhancement Ratio |
|---|---|---|---|
| Control | 3.34 ± 0.90 | 0.003 | - |
| F1 | 21.37 ± 0.01 *# | 0.021 | 6.4 |
| F2 | 23.71 ± 2.5 *# | 0.037 | 9.8 |
| F3 | 12.13 ± 1.8 * | 0.013 | 3.63 |
| E | 11.71 ± 1.0 * | 0.012 | 3.51 |
| Formulation | Zone of Inhibition (mm) |
|---|---|
| Azithromycin | 7.82 ± 0.01 |
| F1 | 10.0 ± 0.9 |
| F2 | 26.4 ± 0.3 |
| F3 | 18.1 ± 0.8 |
| E | 6.55 ± 0.9 |
| TQ | 1.8 ± 0.1 |
| Blank formulation | 0 |
Disclaimer/Publisher’s Note: The statements, opinions and data contained in all publications are solely those of the individual author(s) and contributor(s) and not of MDPI and/or the editor(s). MDPI and/or the editor(s) disclaim responsibility for any injury to people or property resulting from any ideas, methods, instructions or products referred to in the content. |
© 2024 by the authors. Licensee MDPI, Basel, Switzerland. This article is an open access article distributed under the terms and conditions of the Creative Commons Attribution (CC BY) license (https://creativecommons.org/licenses/by/4.0/).
Share and Cite
Mohd, H.; Dopierała, K.; Zidar, A.; Virani, A.; Michniak-Kohn, B. Effect of Edge Activator Combinations in Transethosomal Formulations for Skin Delivery of Thymoquinone via Langmuir Technique. Sci. Pharm. 2024, 92, 29. https://doi.org/10.3390/scipharm92020029
Mohd H, Dopierała K, Zidar A, Virani A, Michniak-Kohn B. Effect of Edge Activator Combinations in Transethosomal Formulations for Skin Delivery of Thymoquinone via Langmuir Technique. Scientia Pharmaceutica. 2024; 92(2):29. https://doi.org/10.3390/scipharm92020029
Chicago/Turabian StyleMohd, Hana, Katarzyna Dopierała, Anze Zidar, Amitkumar Virani, and Bozena Michniak-Kohn. 2024. "Effect of Edge Activator Combinations in Transethosomal Formulations for Skin Delivery of Thymoquinone via Langmuir Technique" Scientia Pharmaceutica 92, no. 2: 29. https://doi.org/10.3390/scipharm92020029
APA StyleMohd, H., Dopierała, K., Zidar, A., Virani, A., & Michniak-Kohn, B. (2024). Effect of Edge Activator Combinations in Transethosomal Formulations for Skin Delivery of Thymoquinone via Langmuir Technique. Scientia Pharmaceutica, 92(2), 29. https://doi.org/10.3390/scipharm92020029

